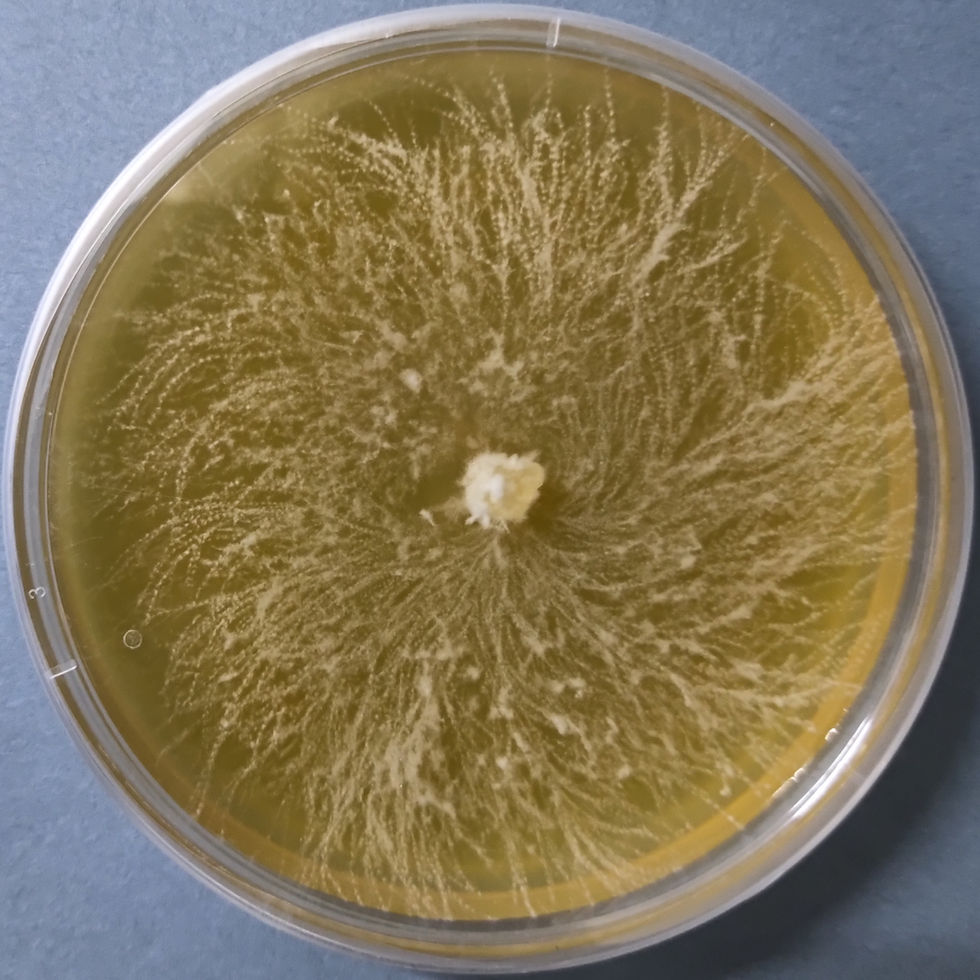
Heat tolerant Lion's mane Culture buy online india

Heat tolerant Lion's mane Culture (Hericium erinaceus)
₹2,500.00
20%OFF on any 5
Resilient, Brain-Boosting Mushroom Culture for Warm Climates
ThisHeat tolerant Lion's mane Hericium erinaceous is specially selected for its adaptability to higher temperatures, making it ideal for tropical and subtropical mushroom cultivators. Known for its unique appearance and powerful nootropic benefits, Lion’s Mane is highly valued in culinary and medicinal markets.
Key Features:
Species: Hericium erinaceus (Lion’s Mane Mushroom)
Strain Type: Heat-tolerant than the cold strain.
Format: Pure culture on PDA (Potato Dextrose Agar) plate
Use: Suitable for mother spawn production and cultivation
Growth Conditions: Thrives in temperatures up to 18-22°C
Health Benefits: Supports brain health, nerve regeneration, and cognitive function
Flavor & Texture: Seafood-like flavor with a tender, meaty texture when cooked
Storage: Refrigerate at 4–8°C; use within 6 months for best viability
Why Choose This Strain?
This heat-tolerant variant enables successful Lion's Mane cultivation in warmer regions where standard strains struggle. Whether you’re a small-scale grower or a commercial cultivator, this plate provides a strong, fast-growing mycelial base.
Quantity